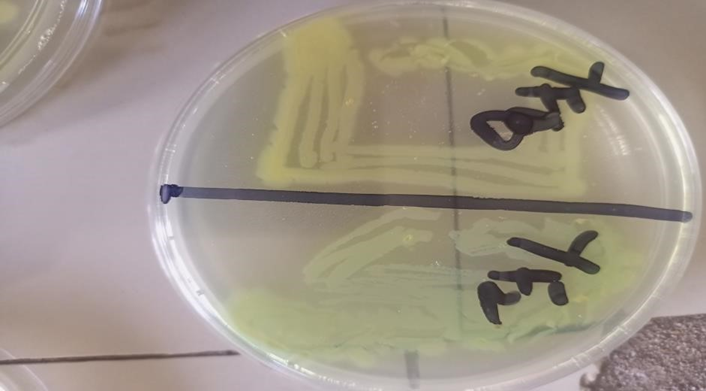

|
Greener Journal of Epidemiology and Public Health ISSN: 2354-2381 Vol. 14(1), pp. 14-19, 2026 Copyright ©2026, Creative Commons Attribution 4.0 International. |
|
Prevalence and Antimicrobial Resistance Patterns of Pseudomonas aeruginosa Isolated from Sputum samples of Patients with Lower Respiratory Tract Infections in Amassoma, Nigeria
Didi Baraikio
Department of Pharmaceutical Microbiology & Biotechnology, Faculty of Pharmacy, Niger Delta University, Wilberforce- Island, Bayelsa State.
|
ABSTRACT |
|||
|
Background: Pseudomonas aeruginosa are Gram -negative bacteria capable of causing a wide range of infections. They often exhibit high levels of resistance to multiple antibiotics, which can lead to significant morbidity and mortality, particularly in immune-compromised individuals. Methods: Three hundred and seventy- eight (378) sputum samples were obtained from patients with Lower respiratory tract infection. The samples were inoculated onto blood agar and MacConkey agar plates and incubated at 37°C for 24 hours. The isolates obtained were identified based on colony morphology, Gram staining and standard biochemical tests. Pure isolates were subsequently sub cultured on Cetrimide agar for confirmatory identification. Antimicrobial susceptibility testing was carried out on Mueller-Hinton agar using Kirby-Bauer disc diffusion method. Results: Out of the 378 sputum samples examined, 53 Pseudomonas aeruginosa isolates were recovered. Of these, 29(54.7%) were obtained from females while 24(45.2%) were obtained from males. The highest frequency of isolation was observed in the 45-54 age group with 18(33.9%) isolates, followed by the 35-44 years age group which accounted for 15(28.3%).Antimicrobial susceptibility testing showed that the isolates exhibited resistance to tetracycline (94.3%), Co-trimoxazole (90.4%), Ceftriaxone (79.2%), nitrofurantoin (73.5%) and amoxicillin/ clavulanic acid (64.1%). Conclusion: This research has demonstrated the presence of Pseudomonas aeruginosa among analyzed sputum samples of patients attending medical facilities, with antibiotic resistance. The research emphasized the need for continuous monitoring of antimicrobial resistance pattern and the judicious antibiotics use.
|
|||
|
ARTICLE’S INFO |
|||
|
Article No.: 022826030 Type: Research Full Text: PDF, PHP, HTML, EPUB, MP3 DOI: 10.15580/gjeph.2026.1.022826030
Accepted: 02/03/2026 Published: 17/03/2026
Keywords: Lower respiratory tract infection, Pseudomonas aeruginosa, Antibiotic resistance |
*Corresponding Author
Didi Baraikio
E-mail: simply4didi@yahoo.com;
Tel: +2348035391089
ORCID: 0009-0004-8919-6624
|
Article’s QR code |
|
|
|
|
|
|
INTRODUCTION
Pseudomonas aeruginosa is a Gram-negative bacterium that can be found alone, in pairs, or sometimes in short chains. As an opportunistic nosocomial pathogen, Pseudomonas aeruginosa, causes a variety of infections and significantly impairs the immune system of patients. Pseudomonas aeruginosa, regrettably, exhibits resistance to several antibiotics, endangering the choice of the best course of action (Arora et al., 2011).
Increasing numbers of Pseudomonas aeruginosa isolates are being recovered from the respiratory tract (Gellatly et al., 2013). Although, the organism may colonize the respiratory system without necessarily causing disease, its presence can still pose a potential risk. This is largely due to its high level of resistance to many antibiotics; and even the drugs that remain effective may be associated with adverse effects, making treatment more challenging (Lee, et al., 2015). In chronic, progressive infectious and inflammatory pulmonary condition, such as severe pneumonia in individuals with weakened immune systems, the lung is a primary site for bacterial colonization and infection (Gibson et al., 2003; Sadikot et al., 2005). Isolation of P. aeruginosa from sputum holds important clinical significance, especially in patients with chronic respiratory diseases or compromised immune systems. Its detection often reflects both colonization and active infection, which can adversely affect lung function, increased morbidity and mortality, and reduce overall quality of life. (WHO, 2017).
A poor host defense system and antibiotic-resistant bacteria are the two main causes of the high mortality rate linked to these diseases. Since there are few antimicrobial medicines that have consistent efficacy against this infamous bacterium, resistance to widely used antimicrobial drugs is becoming a recognized public health concern and a growing clinical issue. Pseudomonas aeruginosa is naturally resistant to a variety of antimicrobial treatments (Thornton et al., 2004).
Multidrug-resistant (MDR) Pseudomonas aeruginosa has emerged as a significant issue. The production of chromosomally encoded beta-lactamases, aminoglycoside-modifying enzymes via horizontal gene transfer, and chromosomal gene mutations (target site, efflux mutations), which are the target of fluoroquinolones, especially ciprofloxacin, are some of the mechanisms that may contribute to Pseudomonas aeruginosa's microbial resistance (Liverrmore, 2000; Arora et al., 2011).
This study aimed to determine the prevalence and antibiotic resistance pattern of Pseudomonas aeruginosa among lower respiratory tract infection patients in Amassoma, Nigeria.
MATERIALS AND METHOD
Study Area/ Population
A cross- sectional research was carried out on patients age groups 15-54 who were clinically diagnosed with lower respiratory tract infection, with symptoms of chest pain, cough, fever and other associated symptoms from selected hospitals in Amassoma, Bayelsa State (General Hospital Amassoma, Tantua Hospital Amassoma and Health Clinic situated at the Niger Delta University Campus, Amassoma). About 5% of those who participated in the research have used antibiotics prior to attending the medical facilities where samples were obtained. Ethical approval was obtained and consent forms were signed by participants prior to sample collection. Samples were obtained within a period of one (1) year, from October, 2024-October 2025 and the research was completed in January 2026. Participants were selected using random Sampling.
Sample Size
The determination of sample size was done using Yamane’s formula as modified and described by Adzani et al. (2021).
N= N_____
K+N (e) 2
Where: N=Population of Study
K=Constant (1)
E=degree of error expected
N=Sample size
With a population of 6,970 according to the 2016 census and a 5% error margin, the sample size calculated was 378 participants.
Sample Collection/Identification
A total of 378 sputum samples were obtained from patients who were clinically diagnosed with Lower respiratory tract infection. Early morning sputum was used for the research. Patients were asked to cough deeply into sterile containers. With the aid of sterile swab, sputum samples were inoculated onto blood and Mac-Conkey agar, incubated at 37°C for 24 hours. Identification was made with Basic Microbiological methods which includes colony morphology, Gram staining, oxidase, Indole, catalase and coagulase tests .Pure isolates were sub cultured on Cetrimide agar for production of blue green pigment pyocyanin which served as confirmatory test.
Gram staining
Gram staining was performed following protocol by Cheesbrough (2006) .Addition of crystal violet to a prepared smear on a slide for 60 second was done and the stain was rinsed with water. Iodine was added for 60 seconds and rinsed with water. Alcohol which serves as the decolorizer was added. It was rinsed with water for 5 minutes. The next stage was the addition of neutral red stain for 2 minutes. It was rinsed water and allowed to dry. The smear was viewed under the microscope using 40x and 100 x magnification.
Oxidase test
A piece of filter paper was soaked in kovac’s reagent and allowed to dry. A colony of 16-24 culture was picked with an inoculating loop and rubbed on the filter paper and color change was observed.
Indole Test
Small quantity of microbial culture was introduced into tryptone broth in a test tube and incubated for 24-48 hours at 350C. Five (5) drops of Kovac’s reagent was added to the tube and observation was made.
Catalase Test
With an inoculating loop, small amount of an 18-24 hour test organism was placed on a microscopic glass slide. A drop of 3% hydrogen peroxide was added to the slide. Observation of bubble as positive result was done.
Coagulase Test
Zero point five (0.5) ml of plasma was transferred to test tube. Two colonies of the isolates were emulsified in the plasma and incubated. Agglutination was checked for at intervals within the next 4 hours for positive result.
Antibiotic susceptibility test
Antimicrobial susceptibility testing was performed according to the guidelines of the clinical and Laboratory standard institute (CLSI, 2021). The inoculum for antimicrobial susceptibility testing was prepared by selecting 3-5 well isolated colonies of each pure bacterial isolate from an overnight culture. The colonies were aseptically transferred into a sterile tube containing 5ml of 0.9% normal saline and mixed to form a homogenous suspension. The turbidity was adjusted to match that of a 0.5 McFarland standard, corresponding to approximately 1×108 CFU/ml, to ensure a consistent inoculum. Sterile swabs were then used to evenly inoculate Mueller- Hinton agar plates, which were allowed to dry before placing antibiotic discs (tetracycline, co-trimoxazole, ceftriaxone, nitrofurantoin, amoxicillin/clavulinic acid, tazobactam/piperacillin, clindamycin, ciprofloxacin, gentamicin, levofloxacin, and ofloxacin). The quality control strain Pseudomonas aeruginosa ATCC 27853 was used to validate the antimicrobial sensitivity test. All plates were then incubated for 24 hours at 37 °C. Inhibitory zones were measured in millimeters (mm).
Statistical Analysis
Statistical analysis was performed with SPSS 21. Data was analyzed using descriptive analysis. The chi square test was used to assess the association between sexes.
RESULTS
A total of fifty-three (53) isolates were obtained from the three hundred and seventy eight (378) sputum samples examined. Chi square analysis showed no significant association between the sexes and the occurrence of isolates. Females accounted for 29(54.7%) isolates while males had 24(45.2%). The difference was not statistically significant (X2 = 0.47, df = 1, p≥ 0.05). Age group 45-54 had the highest isolation of Pseudomonas aeruginosa with a total of 18(33.96%), followed by age group 35-44, 15(28.30%) as shown in Figure 1.

Figure 1: Distribution of Pseudomonas aeruginosa isolates by Age and Sex
Plate 1: Colonies of Pseudomonas aeruginosa on Cetrimide agar
Plate 2: Colonies of Pseudomonas aeruginosa on Cetrimide agar
The susceptibility test results of P. aeruginosa in this study revealed resistance of the isolates to tetracycline (94.3%), Co-trimoxazole (90.4%), Ceftriaxone (79.2%), nitrofurantoin (73.5%) and amoxicillin/ clavulanic acid (64.1%); moderate resistance to tazobactam/ piperacillin (54.7%) and clindamycin (56.6%). However, there was high susceptibility to ciprofloxacin (100%), gentamicin (94.3%), levofloxacin (90.4%) and ofloxacin (84.9%) as shown in table 1.
Table 1: Antibiotic resistance pattern of Pseudomonas aeruginosa isolates
|
S/N |
Antimicrobial Agent |
Number Resistance (%) |
Number Susceptible (%) |
|
1 |
Co-trimoxazole |
48(90.4) |
5 (9.4) |
|
2 |
Ofloxacin |
8(15.0) |
45(84.9) |
|
3 |
Tetracycline |
50(94.3) |
3(5.6) |
|
4 |
Amoxicilin/Clavunic acid |
34(64.1) |
19(35.8) |
|
5 |
Gentamicin |
3(5.6) |
50(94.3) |
|
6 |
Levofloxacin |
5(9.4) |
48(90.4) |
|
7 |
Ceftriaxone |
42(79.2) |
11(20.7) |
|
8 |
Nitrofurantoin |
39(73.5) |
14(26.4) |
|
9 |
Clindamycin |
30(56.6) |
23(43.3) |
|
10 |
Ciprofloxacin |
0(0.0) |
53(100.0) |
|
11 |
Tazobactam/piperacillin |
29(54.7) |
24(45.2) |
DISCUSSION
The present study revealed a total of fifty-three (53) Pseudomonas aeruginosa isolation from clinical sputum. Isolation was higher in females (54.7%) than males (45.2%). This does not agree with research by Saroj et al. (2016), Ali et al. (2018) and Ahmed et al. (2012) where males had the highest occurrence. Increased exposure to healthcare may be the cause of the higher percentage among women. Compared to men, women appear to seek medical attention more frequently and earlier (Thompson et al., 2016).
The highest number of isolates occurred in the 45–54 age group, which is in agreement with studies conducted by Saroj et al. (2016), Ali et al. (2018) and AL-Magrami et al. 2018 where age group ≥41, ≥ 60 and ≥ 50 respectively had the highest isolate. Reduced immunity, extended hospital stays, and other related comorbidities in these age groups may be the cause (Saroj et al., 2016).
The present study showed high resistance to tetracycline (94.3%), co-trimoxazole (90.4%), ceftriaxone (79.2%), nitrofurantoin (73.5%) and amoxicillin/ clavulinic acid (64.1%); moderate resistance to tazobactam/ piperacillin (54.7%) and clindamycin (56.6%). This is in agreement with Alyahawi et al. (2018) where there was 96.2 resistance to amoxicillin/ clavulinic acid, ceftriaxone 78%, nitrofurantoin 88%, cotrimoxzole 80.5%. However their research showed 77.2% susceptibility to piperacillin/tazobactam .Research by AL-Magrami et al (2018) showed 100% resistance to ceftriaxone and ciprofloxacin. The study conducted by Abdulrasheed et al.(2020) on the antimicrobial susceptibility patterns and bacterial isolates in septicemia patients attending FMC Yenagoa reported that Pseudomonas isolates exhibited 100% resistance to tetracycline, ceftriaxone and amoxicillin-clavulanic acid.
The production of beta-lactamases, such as AmpC cephalosporinase or extended-spectrum beta-lactamases (ESBLs), which break down the beta-lactam rings and make the medication ineffective, is suggested by resistance to the beta-lactam antibiotics (amoxicillin/clavulinic acid, ceftriaxone) (Bush and Bradford, 2020).
The pressure on bacterial selection brought on by improper drug use and questionable quality sold may account for the concerning rates of bacterial resistance (Ndoutamia et al., 2017). P. aeruginosa has inherent resistance to beta-lactam antibiotics due to its low outer membrane permeability, efflux pumps, other genetic characteristics, and capacity to build biofilms (Karl and Lain, 2021).
Tetracycline resistance is likely caused by ribosomal protection proteins that prevent tetracycline binding or efflux pump-mediated drug ejection (Grossman, 2016). The isolates' resistance to clindamycin may indicate the presence of an active efflux mechanism or a change in the target ribosome. Because of its limited permeability and efflux pump function, Pseudomonas aeruginosa is inherently resistant to clindamycin (Nikaido, 2009). The observed resistance to nitrofurantoin is consistent with intrinsic resistance in Pseudomonas aeruginosa (Cunha et al., 2011).
An interesting part of the study is the fact that high susceptibility was observed in Ciprofloxacin (100%), gentamicin (94.3%), levofloxacin (90.4%) and ofloxacin (84.9%).These drugs proved to be the most effective in the current study. However, previous research by AL-Magrami et al. (2018) showed 100% resistance to ciprofloxacin, 85.7% to levofloxacin and 35.7% to gentamicin. On the other hand, Ali et al. (2018), had a susceptibility rate of 71.5%% to ciprofloxacin, 66% to Levofloxacin, and 56% to Gentamicin. Strong broad-spectrum antibiotics, fluoroquinolones mostly target Gram-negative bacteria but can also target some Gram-positive ones. One of their advantages is that they work well against bacteria that are resistant to many drugs (Cunha, 1994). All isolates' gentamicin sensitivity attests to the continued effectiveness of aminoglycosides against Pseudomonas aeruginosa (Ramirez and Tolmasky, 2017).
CONCLUSION
This research confirmed the occurrence of Pseudomonas aeruginosa in 378 sputum samples examined, with fifty-three (53) isolates recovered. A slightly higher prevalence was observed among females compared to males. The highest occurrence of isolates was recorded in individuals within the 45-54 age group. The antimicrobial susceptibility pattern showed resistance of Pseudomonas aeruginosa to commonly used antibiotics. This shows the challenge posed by Pseudomonas aeruginosa in lower respiratory infections .Thus, routine susceptibility testing and appropriate infections control measures are essential to ensure effective management and control of infections caused by Pseudomonas aeruginosa.
Acknowledgment
The author appreciates the staff of Pharmaceutical Microbiology and Biotechnology, Niger Delta University, Amassoma.
Conflict of interest
The author declare no conflict of interest
REFERENCES
Abdulrasheed, B. A., John, E.,Tolulope, A.(2020). Antimicrobial Susceptibility Patterns and Bacterial isolates in Septicemia Patients Attending FMC Yenagoa. International journal of Research and Scientific innovation,7(4),134-143.
Ahmed, S.M., Jakribettu, R.P., Kottakutty, S., Arya, B., Shakir, V.P.A. (2012). An emerging multi-drug resistant pathogen in a tertiary care centre in North Kerala. Annals. Biol. Res., 3(6): 2794–99.
Ali A, Alhomidi AM, Al-Henhena N. (2018).Prevalence of Pseudomonas aeruginosa (P. aeruginosa) and antimicrobial susceptibility patterns at a private hospital in Sana’a,Yemen. Universal Journal of Pharmaceutical Research, 3(4): 12-18. https://doi.org/10.22270/ujpr.v3i4.177
AL-Magrami, R. T.F., Al-Shamahy, H.A.(2018). Pseudomonas aeruginosa skin-nasopharyngeal Colonization in the in-patients: prevalence, risk factors and antibiotic resistance in tertiary hospitals in Sana’a city- Yemen. Universal Journal of Pharmaceutical Research, 3(6), 17-22. https://doi.org/10.22270/ujpr.v3i6.219
Arora, D., Jindal, N., Kumar, R., Romit. (2011). Emerging antibiotic resistance in Pseudomonas aeruginosa. Int. J. Pharm. Sci., 3(2): 82–4.)
Bush, K., Bradford, P.A. (2020).Epidemiology of β-Lactamase-producing pathogens. Clin Microbiol Rev, 33(2):e00047-19. doi:10.1128/CMR.00047-19.
Cheesbrough, M. (2006). District Laboratory practice in Tropical Countries Part 2.Cambridge University Press, Cambridge, 38-70.
Clinical and Laboratory Standards Institute (CLSI). (2021). Performance standards for antimicrobial susceptibility testing (31st Ed.).
Cunha B.A.The fluoroquinolones for urinary tract infections: A review.Adv Ther.1994, 11(6):277-96.
Cunha, B. A.,(2011). Nitrofurantoin: Preferred Empirical Therapy for Community Acquired Lower respiratory Tract infections. Mayo Clin Proc, 86(12), 1243-1244.doi:10.4065/mcp.2011.0411.
Gellatly, S. L., & Hancock, R. E. W. (2013). Pseudomonas aeruginosa: New insights into pathogenesis and host defenses. FEMS Microbiology Reviews, 37(3), 409–453.
Gibson, R. L., Burns, J. L., & Ramsey, B. W. (2003). Pathophysiology and management of pulmonary infections in cystic fibrosis. American Journal of Respiratory and Critical Care Medicine, 168(8), 789–798.
Grossman, T.H.(2016). Tetracycline antibiotics and resistance. Cold Spring Harb. Perspect. Med. 6(4), a025387
Indu Biswal, Balvinder Singh Arora, Dimple Kasana, Neetushree. 2014. Incidence of multidrug resistant Pseudomonas Aeruginosa isolated from Burn Patients and Environment of Teaching Institution. J. clin. Diag. Res, 8(5).
Lee, J., & Zhang, L. (2015). The hierarchy quorum sensing network in Pseudomonas aeruginosa. Protein & Cell, 6(1), 26–41.
Livermore, D. M. (2002). Multiple mechanisms of antimicrobial resistance in Pseudomonas aeruginosa: Our worst nightmare? Clinical Infectious Diseases, 34(5), 634–640.
Karl, A., & Lain, L. L. (2021). Β-lactam Resistance in Pseudomonas aeruginosa: Current Status, Future Prospect. Pathogens, 10(12), 1638.
Ndoutamia, G., Fissou, H.Y., Nadjilem, D & Gatsing, D.(2017).Perception, Knowledge and Use of Antiiotic among Communities in Chad. African journal of Pharmacy and pharmacology, 11,260-265
Nikaido,, H., (2009).Multidrug Resistance in Bacteria. Annu Rev Biochem, 78:119-146. doi:10,1146/annurev.biochem.78.082907.145923
Ramirez, M.S.,& Tolmasky, M.E.(2010). Aminoglycoside modifying enzymes. Drug Resis Upd,13(6), 151-171. https://doi.org/10.1016/j.drup.2010.08.003 22.
Sadikot, R. T., Blackwell, T. S., Christman, J. W., & Prince, A. S. (2005). Pathogen-host interactions in Pseudomonas aeruginosa pneumonia. American Journal of Respiratory and Critical Care Medicine, 171(11), 1307–1314.
Saroj, G., Suhani, M. S., & Jyoti. (2016). Isolation of Pseudomonas aeruginosa from various Clinical Isolates and it Antimicrobial Resistance Pattern in a Tertiary Care Hospital. Int. J. Curr. Microbiol. App. Sci. 5(3): 247-253. doi: http://dx.doi.org/10.20546/ijcmas.2016.503.030
Strateva, T., & Yordanov, V.(2009). Pseudomonas aeruginosa- a phenomenon of bacterial resistance. J Med Microb , 58(9),1133-1148. https://doi.org/10.1099/jmm.0.009142-0 23
Thompson, A.E., Anisimowicz, Y.,Miedema, B et al(2016). The influence of gender and other patient characteristics on health care seeking behavior: a QUALICOPC study. BMC Fam Pract, 17: 38.
Thornton, J. P., Hawkey, P. M., & Livermore, D. M. (2004). Multidrug resistance in clinical isolates of Pseudomonas aeruginosa. Journal of Antimicrobial Chemotherapy, 53(6), 868–874.
World Health Organization (WHO). (2017). Global priority list of antibiotic-resistant bacteria to guide research, discovery, and development of new antibiotics.
|
Cite this Article: Baraikio, D (2026). Prevalence and Antimicrobial Resistance Patterns of Pseudomonas aeruginosa Isolated from Sputum samples of Patients with Lower Respiratory Tract Infections in Amassoma, Nigeria. Greener Journal of Epidemiology and Public Health, 14(1): 14-19, https://doi.org/10.15580/gjeph.2026.1.022826030. |